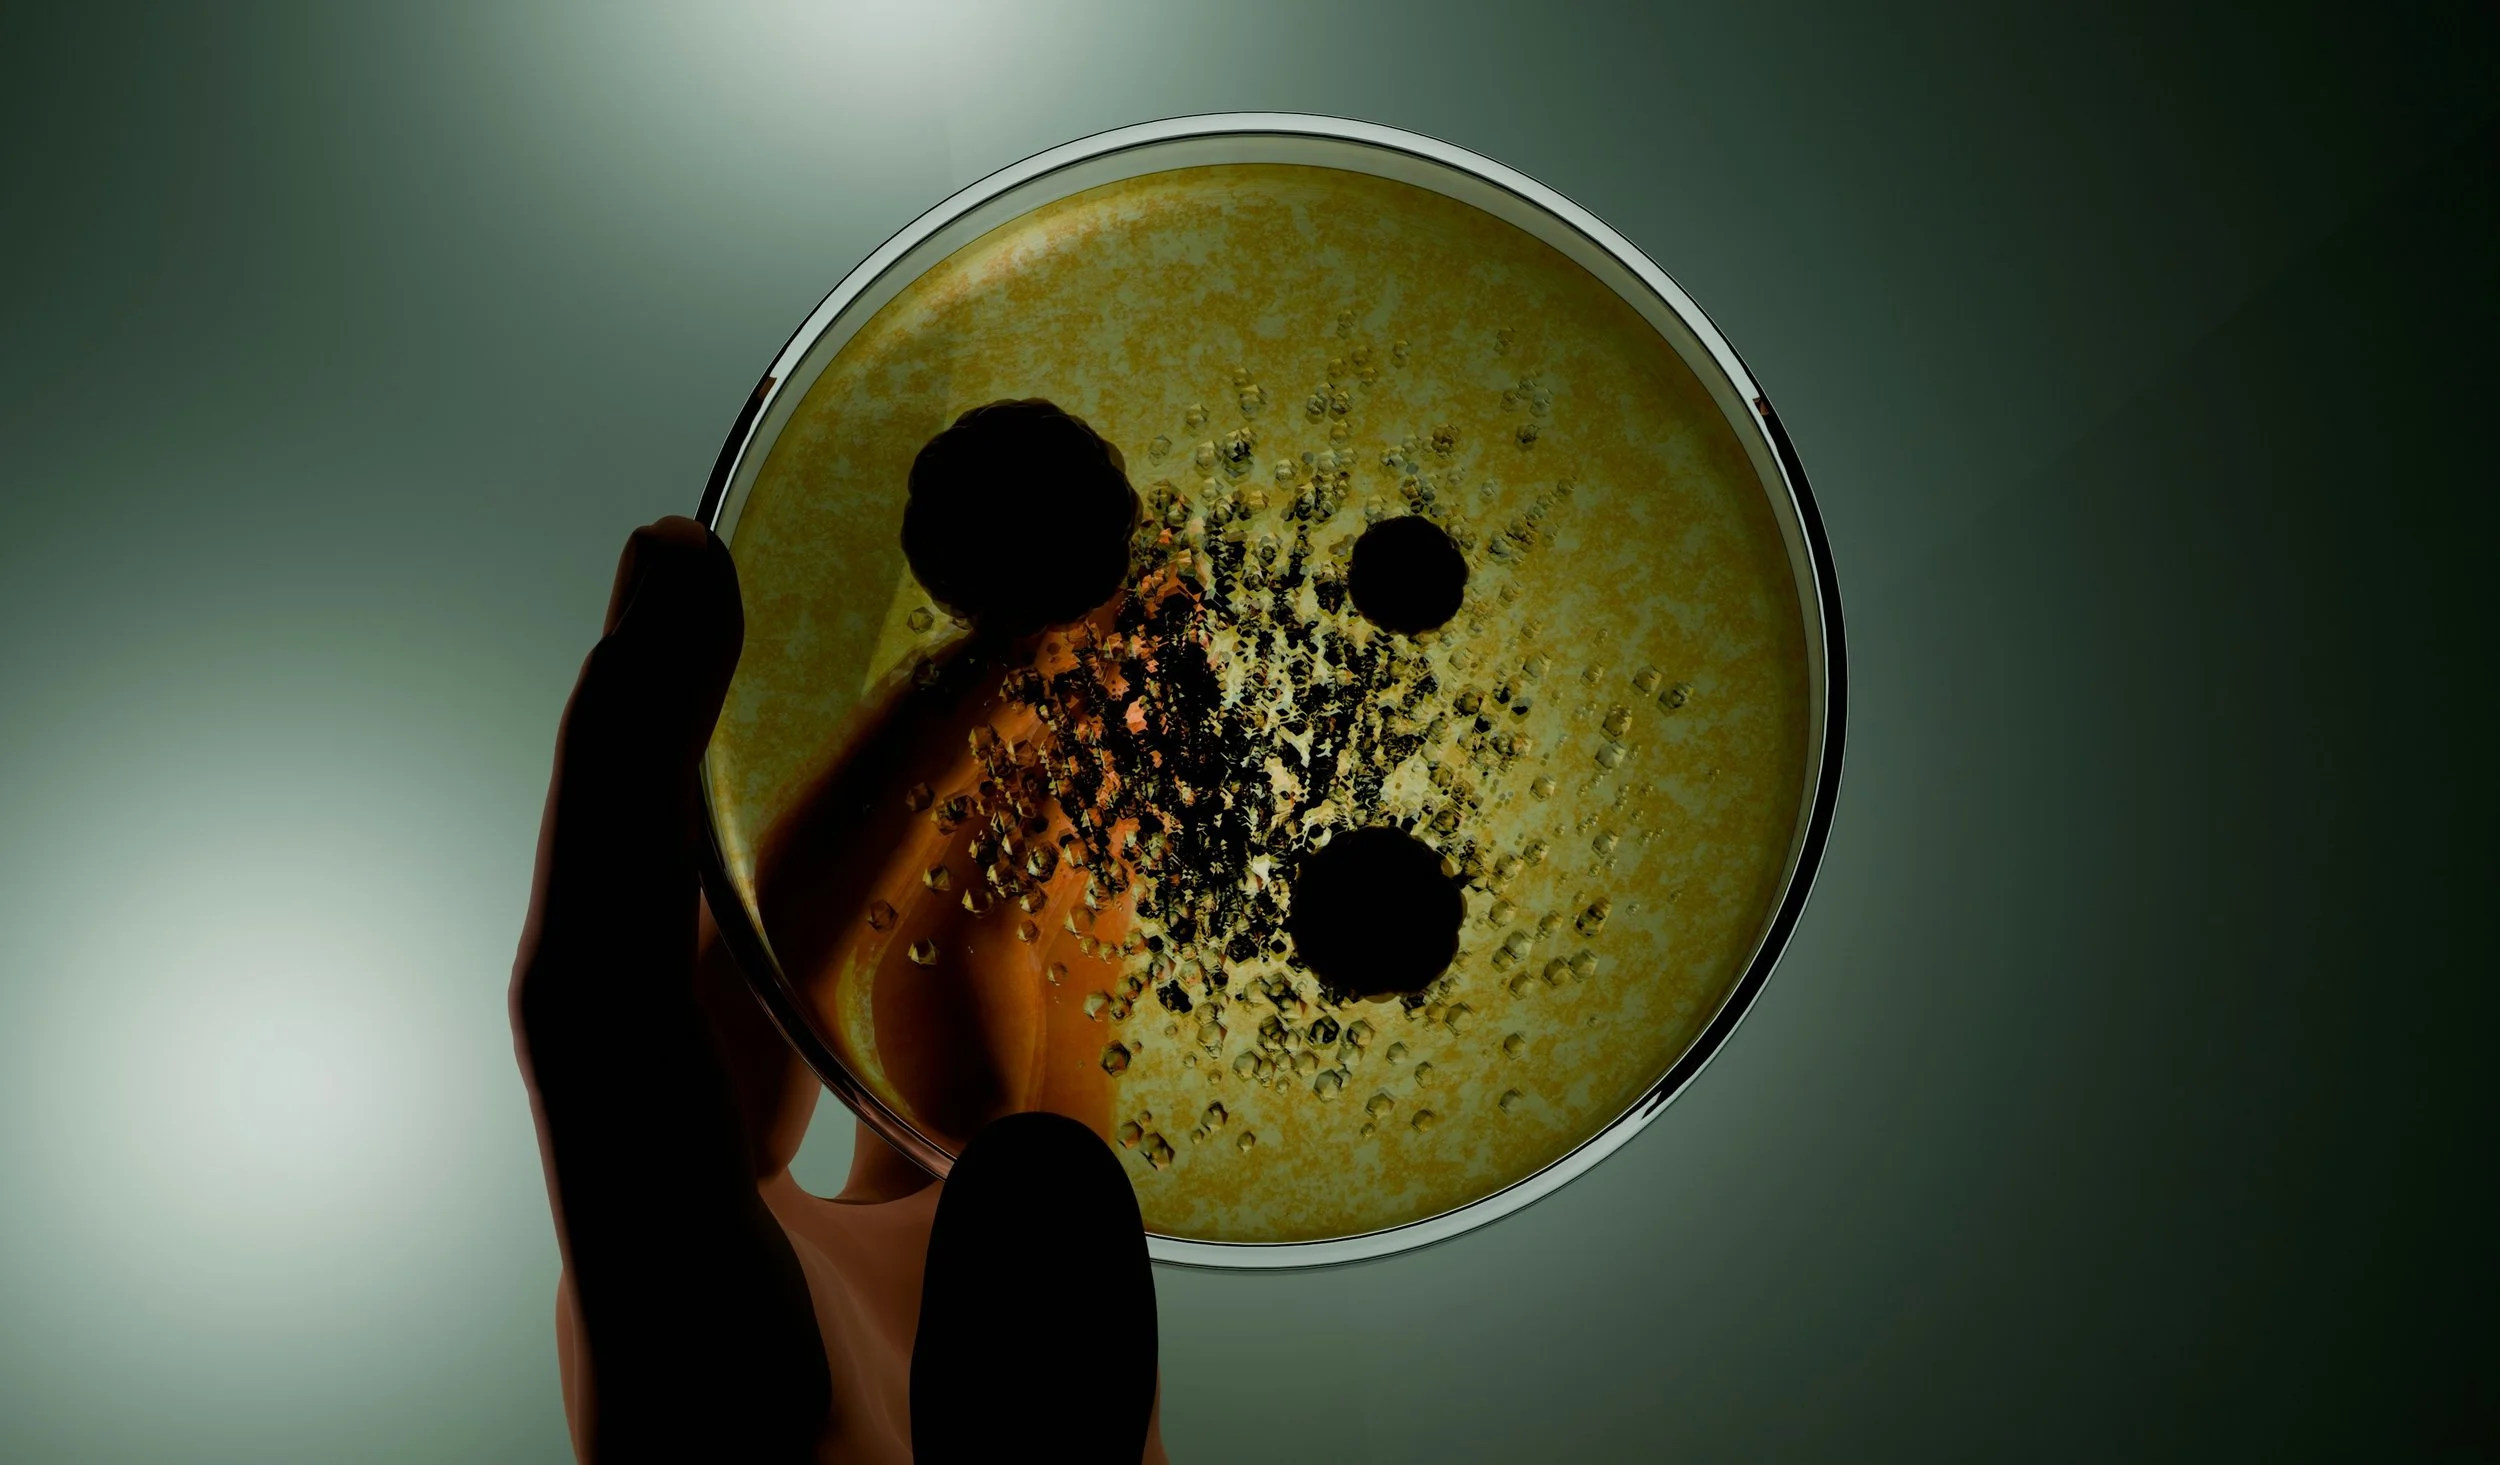

Tried the supplements, the diets, the quick fixes? This is what comes after all of that.
A structured entry into integrative care designed to provide clarity, identify key imbalances, and begin a targeted, personalized strategy.
Functional Diagnostic Wellness


Foundational FDN Health Assessment
This package allows for deeper investigation and ongoing refinement—integrating functional diagnostics, clinical insight, and a systems-based approach to restore balance across the body.
Includes:
3 × 60-minute one-on-one consultations
Comprehensive health review & symptom mapping
Functional, FDN-informed guidance and initial strategy
Interpretation of up to two functional lab tests (if available)
Targeted supplement recommendations to support key imbalances
Early-stage protocol refinement based on your response

Essentials FDN Health Assessment
This package allows for a deeper evaluation over time—combining functional insight, clinical guidance, and progressive refinement to initiate meaningful change.
Includes:
5 × 60-minute one-on-one consultations
In-depth functional health analysis & pattern recognition
Personalized, evolving strategy tailored to your needs
Interpretation and correlation of up to three functional lab tests (if available)
Phased supplement protocol aligned with your H.I.D.D.E.N.® patterns
Ongoing refinement based on progress and response
Priority continuity of care throughout the process

Comprehensive FDN Integrative Health
A comprehensive, data-driven health optimization process designed to uncover, correlate, and address your unique H.I.D.D.E.N.® patterns through advanced functional assessment and a fully personalized strategy.
This is a complete, guided experience—integrating testing, clinical insight, and ongoing refinement to support deep, lasting transformation.
Includes:
6 × 60-minute one-on-one consultations
Comprehensive functional health assessment & system mapping
Full interpretation and correlation of up to five functional lab tests (if available)
Complete FDN H.I.D.D.E.N.® systems analysis
(Hormonal, Immune, Digestive, Detoxification, Energy, Nervous)Full D.R.E.S.S.® protocol implementation:
Personalized nutrition strategy
Rest & recovery optimization
Exercise and movement guidance
Stress regulation & nervous system support
Targeted, practitioner-grade supplementation plan (phased approach)
Ongoing protocol refinement based on your response
Priority support and continuity of care throughout the process

